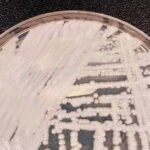

Os brasileiros ainda não sacaram R$ 7,08 bilhões em recursos esquecidos no sistema financeiro, divulgou nesta quarta-feira (7) o Banco Central (BC). Até agora, o Sistema de Valores a Receber (SVR) devolveu R$ 3,93 bilhões, de um total de R$ 11,01 bilhões postos à disposição pelas instituições financeiras.

Em relação ao número de beneficiários, 13.970.528 correntistas resgataram valores. Isso representa apenas 35,93% do total de 38.876.360 correntistas incluídos na lista desde o início do programa, em fevereiro do ano passado.
Entre os que já retiraram valores, 13.477.382 são pessoas físicas e 493.146, pessoas jurídicas. Entre os que ainda não fizeram o resgate, 36.120.242 são pessoas físicas e 2.756.118, pessoas jurídicas.
A maior parte das pessoas e empresas que ainda não fizeram o saque têm direito a pequenas quantias. Os valores a receber de até R$ 10 concentram 62,68% dos beneficiários. Os valores entre R$ 10,01 e R$ 100 correspondem a 25,24% dos correntistas. As quantias entre R$ 100,01 e R$ 1 mil representam 10,31% dos clientes. Só 1,78% tem direito a receber mais de R$ 1 mil.
Depois de ficar fora do ar por quase um ano, o SVR foi reaberto em março, com novas fontes de recursos, um novo sistema de agendamento e a possibilidade de resgate de valores de pessoas falecidas. Em março, informou o BC, foram resgatados R$ 505 milhões esquecidos. Em abril, o valor caiu para R$ 259 milhões.
Melhorias
A nova fase do SVR tem novidades importantes, como impressão de telas e de protocolos de solicitação para compartilhamento no WhatsApp e inclusão de todos os tipos de valores previstos na norma do SVR. Também haverá uma sala de espera virtual, que permite que todos os usuários façam a consulta no mesmo dia, sem a necessidade de um cronograma por ano de nascimento ou de fundação da empresa.
Além dessas melhorias, há a possibilidade de consulta a valores de pessoa falecida, com acesso para herdeiro, testamentário, inventariante ou representante legal. Assim como nas consultas a pessoas vidas, o sistema informa a instituição responsável pelo valor e a faixa de valor. Também há mais transparência para quem tem conta conjunta. Se um dos titulares pedir o resgate de um valor esquecido, o outro, ao entrar no sistema, conseguirá ver as informações: como valor, data e CPF de quem fez o pedido.
Fontes de recursos
Também foram incluídas fontes de recursos esquecidos que não estavam nos lotes do ano passado. Foram acrescentadas contas de pagamento pré ou pós-paga encerradas, contas de registro mantidas por corretoras e distribuidoras encerradas e outros recursos disponíveis nas instituições para devolução.
Além dessas fontes, o SVR engloba os seguintes valores, já disponíveis para saques no ano passado. Eles são os seguintes: contas-corrente ou poupança encerradas; cotas de capital e rateio de sobras líquidas de ex-participantes de cooperativas de crédito; recursos não procurados de grupos de consórcio encerrados; tarifas cobradas indevidamente; e parcelas ou despesas de operações de crédito cobradas indevidamente.
Golpes
O Banco Central aconselha o correntista a ter cuidado com golpes de estelionatários que alegam fazer a intermediação para supostos resgates de valores esquecidos. O órgão ressalta que todos os serviços do Valores a Receber são totalmente gratuitos, que não envia links nem entra em contato para tratar sobre valores a receber ou para confirmar dados pessoais.
O BC também esclarece que apenas a instituição financeira que aparece na consulta do Sistema de Valores a Receber pode contatar o cidadão. O órgão também pede que nenhum cidadão forneça senhas e esclarece que ninguém está autorizado a fazer tal tipo de pedido.